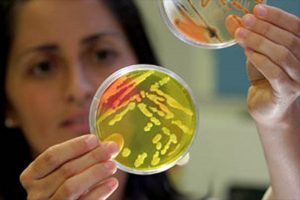

Las asociaciones agrarias españolas UPA y ASAJA pidieron este miércoles 27 de junio a la Comisión Europea (CE) «más acción» de lo que consideran un ataque por parte del gobierno de Trump a las políticas de la PAC desde el principio.
En este sentido, piden contundencia para evitar la subida definitiva de los aranceles de EE.UU. a la aceituna de mesa y un mayor impacto en el sector, que ya sufre las consecuencias de las medidas impuestas por Washington.
En una jornada celebrada en una granja en Huldenberg, en Flandes, el presidente de Interaceituna, Ricardo Serra, criticó que la posición de Bruselas sea «no hacer nada» hasta que se conozca la decisión definitiva del dictamen de la Comisión de Comercio Internacional (ITC, en sus siglas en inglés), que se hará pública el 24 de julio.
Serra consideró que la CE «debería tomar acciones mucho más serias» dado que «ya se ha hecho un daño bastante grande» al sector, con pérdidas de más del 40 % en el mercado estadounidense y consecuencias directas en el empleo.
La medida propuesta por Washington -aumentar los aranceles provisionales actuales, de hasta un 21,60 %, a un 34,75 %- es el resultado de la investigación que abrió el Departamento de Comercio estadounidense en julio del año pasado a raíz de una denuncia de varias empresas locales.
La aplicación de estos aranceles significaría que tienen la posibilidad de bloquear cualquier tipo de exportación
Según las autoridades estadounidenses, la aceituna negra de mesa española se ha exportado al país a precios de «dumping» (competencia desleal) y recibe ayudas comunitarias y españolas que «le confieren ventajas desleales sobre sus competidoras americanas».
Bruselas ha mostrado preocupación dado que ve esta imposición como un ataque a las ayudas de la Política Agrícola Común (PAC), y teme que la administración de Donald Trump pueda aplicarlas a otros productos agrarios.
«Si aplican estos aranceles significa que tienen la posibilidad de bloquear cualquier tipo de exportación», alertó Serra. 
En la misma línea, el representante de UPA en Jaén, Cristóbal Cano, consideró que la UE debe ser «beligerante y poner todos los medios diplomáticos al máximo nivel, porque hoy es la aceituna de mesa y mañana pueden ser otros sectores de mayor importancia».
«Hay que ser firme en la defensa del sector agroalimentario, porque no es un ataque a la aceituna de mesa sino a la PAC, desde que se inició el procedimiento las caídas en exportaciones han sido múltiples, exigimos a la UE que tenga al máximo nivel político el sector agrario en Europa», dijo.
El brexit obligaría a ser más competitivos
En el debate celebrado en la granja Hof Ten Bosch, impulsado por la multinacional química y farmacéutica Bayer, que adquirió recientemente Monsanto, participó la eurodiputada del PP Pilar Ayuso, quien defendió que «la PAC asegura unos alimentos más seguros, asequibles y saludables».
«La agricultura española es muy competitiva y tenemos que darle armas para que siga siéndolo y más», subrayó la parlamentaria, quien defendió el uso de la tecnología en el sector y criticó el «rechazo visceral» a las nuevas sustancias.
En esta granja flamenca, activa desde 1890 en el cultivo de patatas, trigo, maíz y que ahora aplica soluciones innovadoras como la agricultura de precisión, «hoteles de abejas», o el uso de drones, Ayuso consideró que «luchar contra esa percepción que tiene la sociedad dará más competitividad al sector».
Según el director adjunto en la dirección general de Agricultura de la CE, Ignacio Seoane, «estos años van a ser fundamentales en el ámbito de la innovación y el desarrollo tecnológico».
«Es la única forma si queremos producir más con menos, y hay que hacer partícipes a los agricultores», advirtió, y consideró esencial «basarse en resultados científicos a la hora de usar determinadas prácticas».
El experto también instó a «dar un mensaje positivo» de la agricultura europea a la sociedad y destacó, entre otros datos, la reducción de emisiones, en un 21 % desde 1990, de nitratos, en un 10 %, o de emisiones de amoniaco en más de un 25 %.
«Hay futuro en el sector agrícola en Europa y buenas perspectivas de crecimiento. Tenemos que potenciar más el desarrollo de capital humano», agregó.
El representante de las organizaciones agrarias europeas, César González, mostró preocupación por cómo el ‘brexit’ pueda afectar al mercado y dijo que obligará «a ser más competitivos».
Tras reunirse este martes con el comisario de Agricultura, Phil Hogan, el presidente de ASAJA, Pedro Barato, vinculó la optimización del presupuesto, después de que la CE presentara una propuesta con un recorte global del 5 % a precios corrientes, «a la innovación tecnológica».

